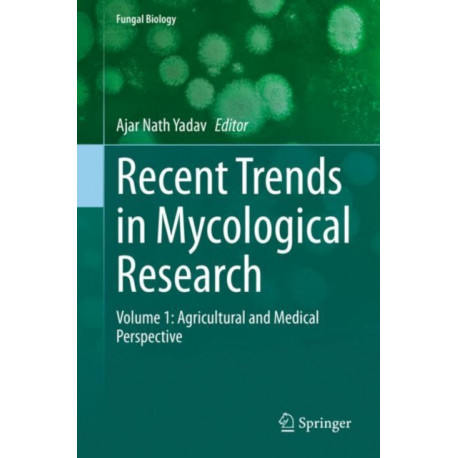

Kurv
Vare
varer
(tom)
Ingen varer
Fastlægges senere
Forsendelse
0,- kr
I alt
Recent Trends in Mycological Research: Volume 1: Agricultural and Medical Perspective
(Bog, Hardback, Engelsk)
Forlag:
Springer Nature Switzerland AG
- Type: Bog
- Format: Hardback
-
Sprog:
Engelsk

- ISBN-13: 9783030606589
- Se flere detaljer ▼
Bemærk: Kan ikke leveres før jul.
Læsernes anmeldelser (0)
Alle detaljer
| Forlag | Springer Nature Switzerland AG |
| Type | Bog |
| Format | Hardback |
| Sprog | Engelsk |
| Udgave | 2021 ed. |
| Udgivelsesdato | 05-02-2021 |
| Første udgivelsesår | 2021 |
| Serie | Fungal Biology |
| Illustrationer | 41 Illustrations, color; 4 Illustrations, black and white |
| Fagredaktør | Ajar Nath Yadav |
| Originalsprog | Switzerland |
| Sideantal | 498 |
| Indbinding | Hardback |
| Forlag | Springer Nature Switzerland AG |
| Sideoplysninger | 498 pages, 41 Illustrations, color; 4 Illustrations, black and white |
| Mål | 235 x 155 |
| ISBN-13 / EAN-13 | 9783030606589 |

